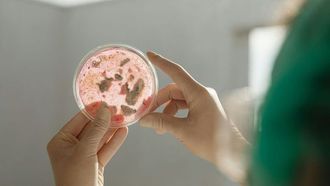
بكتيريا الأمعاء تؤثر على السلوك الاجتماعي

Cognitive Science
- إن الاكتشاف الذي يفيد بأن البشر قادرون على استيعاب جوهر الجملة في غضون 125 م...
- لقد كان الجدل حول ما إذا كانت اللغة ضرورية للتفكير قائماً منذ فترة طويلة، ...
- لقد تم الاعتراف بشكل متزايد بالعلاقة المعقدة بين الكائنات الحية الدقيقة ف...
- في دراسة رائدة حديثة نشرت في مجلة Science Advances، سلط فريق من علماء الأعصاب الإي...
ذهب عيار ٢٤ / Gram
ذهب عيار ٢٢ / Gram
From
AED - Emirati Dirham
To
Advertisement